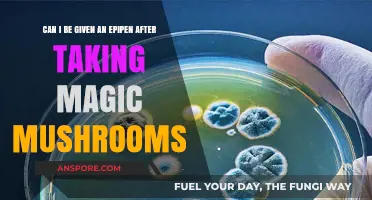
Magic Mushrooms and Epipens: Understanding Potential Risks and Interactions

Baking mushrooms in the oven is a simple and versatile cooking method that allows you to enhance their natural flavors while achieving a tender, slightly crispy texture. Whether you're using button, cremini, portobello, or shiitake mushrooms, the oven provides consistent heat that helps them caramelize and develop a rich, savory taste. This technique is ideal for side dishes, toppings, or as a base for more complex recipes. With minimal prep work and a short cooking time, oven-baked mushrooms are a quick and healthy addition to any meal, offering a delicious way to enjoy this nutrient-packed ingredient.
| Characteristics | Values |
|---|---|
| Can mushrooms be baked in the oven? | Yes |
| Recommended temperature | 375°F to 425°F (190°C to 220°C) |
| Cooking time | 15-25 minutes, depending on size and desired texture |
| Preparation methods | Whole, sliced, or stuffed; toss with olive oil, salt, pepper, and optional herbs/spices |
| Benefits of baking | Enhances flavor, concentrates umami taste, and creates a tender or crispy texture |
| Common seasonings | Garlic, thyme, rosemary, paprika, balsamic vinegar, or Parmesan cheese |
| Serving suggestions | As a side dish, topping for steaks, salads, or pasta, or as an appetizer |
| Storage | Refrigerate in an airtight container for up to 3 days; reheat in oven or skillet |
| Health considerations | Low in calories, rich in vitamins (e.g., D, B), minerals, and antioxidants |
| Varieties suitable for baking | Button, cremini, portobello, shiitake, and oyster mushrooms |
| Tips for best results | Pat mushrooms dry before baking to avoid excess moisture; use a parchment-lined baking sheet |
Explore related products
What You'll Learn
- Preparation Tips: Clean, trim, and season mushrooms before baking for optimal flavor and texture
- Baking Temperature: Best at 375°F-400°F to ensure even cooking without drying out
- Cooking Time: Bake for 15-20 minutes until tender and lightly browned
- Seasoning Ideas: Use garlic, herbs, olive oil, or cheese for enhanced taste
- Serving Suggestions: Pair with salads, pasta, or as a side dish

Preparation Tips: Clean, trim, and season mushrooms before baking for optimal flavor and texture
Baking mushrooms in the oven unlocks a world of flavor and texture, but their delicate nature demands careful preparation. Skipping essential steps like cleaning, trimming, and seasoning can lead to soggy, bland results. Think of it as laying the foundation for a culinary masterpiece: a clean canvas ensures vibrant colors, precise trimming guarantees even cooking, and thoughtful seasoning elevates the natural umami.
Mastering these preparatory steps transforms ordinary mushrooms into a star ingredient, whether you're roasting portobellos for a hearty main course or caramelizing button mushrooms for a savory side dish.
Cleaning: The Gentle Approach
Forget harsh scrubbing that bruises delicate mushroom caps. The key lies in a gentle rinse under cold water, followed by a quick pat dry with a clean kitchen towel. For stubborn dirt, use a damp paper towel or a soft brush specifically designated for mushroom cleaning. Remember, mushrooms act like sponges, absorbing excess moisture. Over-washing leads to watery, mushy textures during baking. Aim for a quick, efficient clean, removing dirt without saturating the mushrooms.
Foraged mushrooms require extra attention. Trim away any woody stems or damaged areas before cleaning.
Trimming: Precision for Even Cooking
Trimming isn't just about aesthetics; it's about ensuring even cooking and maximizing flavor. Remove the tough, fibrous ends of mushroom stems, as they won't soften during baking. For larger varieties like portobellos, consider scooping out the dark gills to create a cavity perfect for stuffing with herbs, cheese, or breadcrumbs. This not only enhances presentation but also allows for creative flavor combinations.
Seasoning: Unleashing Umami Potential
Seasoning is where mushrooms truly shine. A simple sprinkle of salt and pepper is a good starting point, but don't be afraid to experiment. Olive oil, a drizzle of balsamic vinegar, or a sprinkle of dried herbs like thyme, rosemary, or oregano add depth and complexity. For a bolder flavor profile, try a marinade of soy sauce, garlic, and ginger before baking. Remember, mushrooms are naturally umami-rich, so let their inherent savoriness guide your seasoning choices.
The Takeaway: A Symphony of Flavors
By meticulously cleaning, trimming, and seasoning your mushrooms, you're not just preparing them for the oven; you're crafting a culinary experience. Each step contributes to a symphony of flavors and textures, transforming humble fungi into a dish that's both satisfying and memorable. So, the next time you ask yourself, "Can I bake mushrooms in the oven?" remember, the answer is a resounding yes – with the right preparation, the possibilities are endless.
Can Curd and Mushrooms Be Eaten Together? A Healthy Pairing?
You may want to see also

Baking Temperature: Best at 375°F-400°F to ensure even cooking without drying out
Baking mushrooms in the oven at 375°F to 400°F strikes the perfect balance between caramelizing their natural sugars and preserving their tender texture. This temperature range allows the mushrooms to cook evenly, ensuring they release moisture without becoming rubbery or dried out. It’s the sweet spot for achieving a golden-brown exterior while maintaining a juicy, flavorful interior. For best results, preheat your oven for at least 10 minutes before baking to ensure consistent heat distribution.
Consider the size and type of mushrooms when using this temperature range. Larger varieties like portobellos or whole creminis benefit from the higher end of the spectrum (400°F) to develop a crispy edge, while smaller button mushrooms or sliced varieties may fare better at 375°F to prevent overcooking. Always arrange mushrooms in a single layer on a baking sheet lined with parchment paper or lightly oiled to prevent sticking and promote even browning.
A common mistake when baking mushrooms is overcrowding the pan, which traps steam and leads to soggy results. At 375°F-400°F, proper airflow is crucial for achieving that desirable texture. Toss the mushrooms in a light coating of olive oil, salt, and pepper before baking to enhance flavor and ensure they don’t dry out. Baking time typically ranges from 15 to 25 minutes, depending on size and desired doneness—check halfway through and flip for even cooking.
This temperature range isn’t just practical; it’s scientifically sound. Mushrooms are composed of about 90% water, and baking them at too high a temperature causes rapid evaporation, leaving them dry. Conversely, lower temperatures prolong cooking time, making them mushy. At 375°F-400°F, the heat gently coaxes out moisture while concentrating flavors, making it ideal for dishes like roasted mushroom sides, stuffed mushrooms, or even mushroom-based meat alternatives.
For a foolproof finish, pair this temperature with a simple seasoning blend—garlic powder, thyme, or a splash of balsamic vinegar—to elevate the earthy notes of the mushrooms. Whether you’re a novice or a seasoned cook, mastering this temperature range ensures your oven-baked mushrooms are consistently tender, flavorful, and never overcooked. It’s a small detail that makes a big difference in your culinary creations.
Mushrooms and Anxiety: Exploring Nature's Potential for Calming Relief
You may want to see also

Cooking Time: Bake for 15-20 minutes until tender and lightly browned
Baking mushrooms in the oven is a straightforward process that transforms their texture and flavor, but timing is critical. The recommended cooking time of 15-20 minutes at 375°F to 400°F strikes a balance between achieving tenderness and preventing overcooking. This window allows the mushrooms to release moisture, concentrate their earthy flavor, and develop a lightly browned exterior without becoming rubbery or dry. Smaller mushroom varieties like button or cremini may lean toward the 15-minute mark, while larger portobellos may require closer to 20 minutes. Always preheat the oven to ensure consistent heat distribution, as this directly impacts the cooking efficiency and final texture.
From a practical standpoint, the 15-20 minute guideline serves as a starting point, but adjustments may be necessary based on oven variability and personal preference. For instance, if you prefer a softer, more melt-in-your-mouth texture, err on the longer side of the range. Conversely, if you’re aiming for a firmer bite, check for doneness at the 15-minute mark. A key indicator of readiness is the mushroom’s appearance: the edges should be golden-brown, and the caps slightly shriveled but not collapsed. Using a parchment-lined baking sheet also aids in even cooking and prevents sticking, allowing you to monitor browning without disturbing the mushrooms.
Comparatively, baking mushrooms differs from stovetop methods like sautéing or grilling, which often take less time but require more active attention. The oven’s dry heat environment not only cooks the mushrooms but also caramelizes their natural sugars, enhancing their umami flavor. This makes baking an ideal technique for dishes where mushrooms are the star, such as stuffed portobellos or roasted mushroom sides. However, unlike stovetop cooking, oven baking offers less control over moisture levels, so proper preparation—like tossing mushrooms in olive oil and seasoning before baking—is essential to retain juiciness without sogginess.
For those new to baking mushrooms, a pro tip is to set a timer for 12 minutes, then assess progress. This allows you to catch the mushrooms before they overcook, especially if your oven runs hot. Additionally, consider the role of seasoning in the final result: a sprinkle of salt and pepper, a drizzle of olive oil, and herbs like thyme or garlic can elevate the dish without complicating the process. By adhering to the 15-20 minute rule and making minor adjustments based on visual cues, you can consistently achieve tender, flavorful mushrooms that complement any meal.
Mushrooms and Reality: Exploring the Thin Line Between Perception and Illusion
You may want to see also
Explore related products

Seasoning Ideas: Use garlic, herbs, olive oil, or cheese for enhanced taste
Baking mushrooms in the oven is a simple yet versatile method that transforms their texture and flavor. To elevate this dish, seasoning is key. Garlic, herbs, olive oil, and cheese are not just additives; they are flavor architects that can turn a basic bake into a culinary masterpiece. Each ingredient brings its unique profile, and when combined thoughtfully, they create a symphony of tastes that complement the earthy essence of mushrooms.
Garlic, a staple in kitchens worldwide, is a powerhouse of flavor. Minced or sliced, it infuses mushrooms with a savory depth that enhances their natural umami. For optimal results, use 2-3 cloves per pound of mushrooms, ensuring it’s evenly distributed. Roasting garlic alongside mushrooms caramelizes its sugars, mellowing its sharpness while adding a subtle sweetness. A pro tip: toss the mushrooms in olive oil and garlic before baking to create a flavorful base that adheres well to the mushrooms’ surfaces.
Herbs introduce freshness and complexity, balancing the richness of other seasonings. Thyme, rosemary, and parsley are excellent choices, each offering distinct notes. Thyme’s earthy aroma pairs perfectly with mushrooms, while rosemary adds a piney, robust flavor ideal for heartier varieties like portobellos. Fresh herbs should be added toward the end of baking to preserve their brightness, whereas dried herbs can be mixed in pre-bake for deeper infusion. Use 1-2 teaspoons of dried herbs or a handful of fresh leaves per pound of mushrooms for balanced flavor.
Olive oil is more than a cooking medium; it’s a flavor enhancer. Its fruity, slightly peppery notes add a luxurious mouthfeel and help seasonings adhere to the mushrooms. Drizzle 2-3 tablespoons of high-quality extra virgin olive oil over the mushrooms before baking, ensuring they’re well-coated but not drowning. For an extra layer of flavor, infuse the oil with garlic or chili flakes beforehand. This simple step elevates the dish from ordinary to extraordinary.
Cheese, the ultimate indulgence, transforms baked mushrooms into a decadent treat. Parmesan, goat cheese, or mozzarella melt beautifully, adding creaminess and a salty contrast to the mushrooms’ earthiness. Sprinkle grated Parmesan over the mushrooms for a crispy topping, or stuff larger varieties like portobellos with crumbled goat cheese for a gooey center. Use moderation—about 1/4 cup of grated cheese per pound of mushrooms—to avoid overpowering the natural flavors.
Incorporating these seasonings requires balance and creativity. Start with a base of olive oil and garlic, layer in herbs for freshness, and finish with cheese for richness. Experiment with combinations to find your signature blend. Whether you’re aiming for a light, herb-forward dish or a rich, cheesy indulgence, these seasonings ensure your baked mushrooms are anything but ordinary.
Can Abalone Mushrooms Thrive in the Wild? Exploring Natural Growth
You may want to see also

Serving Suggestions: Pair with salads, pasta, or as a side dish
Baked mushrooms, with their rich, umami flavor and tender texture, are a versatile addition to any meal. When considering serving suggestions, think of them as a culinary chameleon—equally at home alongside a crisp salad, tossed with pasta, or standing alone as a side dish. The key lies in balancing their earthy depth with complementary ingredients and textures.
For salads, baked mushrooms add a satisfying heft and savory contrast. Pair them with bitter greens like arugula or frisée, then dress with a bright vinaigrette to cut through their richness. A sprinkle of toasted nuts or crumbled cheese enhances the dish’s complexity. For example, portobello mushrooms baked with garlic and thyme can anchor a warm spinach salad topped with goat cheese and walnuts. Keep portions modest—about 2-3 mushroom caps per serving—to avoid overwhelming the lighter components.
When tossed with pasta, baked mushrooms become a star ingredient rather than a mere garnish. Their concentrated flavor holds its own against hearty sauces like cream-based Alfredo or rustic tomato ragù. For a lighter option, combine them with olive oil, lemon zest, and fresh herbs like parsley or basil. Aim for a 1:1 ratio of mushrooms to pasta to ensure every bite includes their meaty texture. Penne or rigatoni work well, as their ridges capture the mushroom slices.
As a side dish, baked mushrooms shine with minimal competition. Serve them whole or halved, depending on size, and season simply with salt, pepper, and a drizzle of olive oil. A squeeze of lemon just before serving brightens their flavor. Portion control is key here—a ½ cup serving per person complements without overshadowing the main course. For a festive touch, add a sprinkle of fresh herbs or a dollop of garlic aioli.
In all cases, timing matters. Bake mushrooms at 375°F (190°C) for 20-25 minutes, until they’re golden and their edges are crispy. Allow them to rest briefly before serving to retain their juices. Whether paired with salads, pasta, or served solo, baked mushrooms elevate any dish with their versatility and depth.
Exploring the Risks: Can Mushroom Consumption Be Harmful to Health?
You may want to see also
Frequently asked questions
Yes, you can bake mushrooms in the oven. It’s a simple and delicious way to cook them, resulting in a tender and flavorful dish.
Preheat your oven to 375°F (190°C) for baking mushrooms. This temperature ensures they cook evenly without drying out.
Baking time varies, but typically mushrooms take 15–25 minutes in the oven, depending on their size and desired texture.
Yes, gently wipe the mushrooms with a damp cloth or paper towel to remove dirt. Avoid soaking them in water, as they can absorb excess moisture.
Yes, toss the mushrooms in olive oil, salt, pepper, and your choice of herbs or spices before baking to enhance their flavor and prevent sticking.